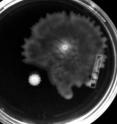
The evolution of hyperswarming, pathogenic bacteria might sound like the plot of a horror film, but such bugs really have repeatedly evolved in a lab, and the good news is that they should be less of a problem to us than their less mobile kin. That's because those hyperswarmers, adorned with multiple whipping flagella, are also much worse at sticking together on surfaces in hard-to-treat biofilms. They might even help us figure out a way to develop anti-biofilm therapies for use in people with cystic fibrosis or other conditions, say researchers who report their findings in <i>Cell Reports</i>, a Cell Press publication, on Aug. 15. The evolution of hyperswarming, pathogenic bacteria might sound like the plot of a horror film, but such bugs really have repeatedly evolved in a lab, and the good news is that they should be less of a problem to us than their less mobile kin. That's because those hyperswarmers, adorned with multiple whipping flagella, are also much worse at sticking together on surfaces in hard-to-treat biofilms. They might even help us figure out a way to develop anti-biofilm therapies for use in people with cystic fibrosis or other conditions, say researchers who report their findings in <i>Cell Reports</i>, a Cell Press publication, on Aug. 15.

Evolution of hyperswarming bacteria could develop anti-biofilm therapies
Related images
(click to enlarge)
The evolution of hyperswarming, pathogenic bacteria might sound like the plot of a horror film, but such bugs really have repeatedly evolved in a lab, and the good news is that they should be less of a problem to us than their less mobile kin. That's because those hyperswarmers, adorned with multiple whipping flagella, are also much worse at sticking together on surfaces in hard-to-treat biofilms. They might even help us figure out a way to develop anti-biofilm therapies for use in people with cystic fibrosis or other conditions, say researchers who report their findings in Cell Reports, a Cell Press publication, on August 15th. The findings are also a textbook example of real-time experimental evolution. What's more, says Joao Xavier of Memorial Sloan Kettering Cancer Center, they are a "unique example of strikingly parallel molecular evolution."
In other words, the evolution that he and his team witnessed was repeatable, all the way down to the molecular level.
The researchers didn't set out with the goal to evolve hyperswarmers, but they did passage Pseudomonas aeruginosa on special plates over a period of days. On those plates, bacteria that could spread out had an advantage in harvesting nutrients from the surface, and within a matter of days, some of those bacteria started hyperswarming.
Investigation of the bacteria showed that P. aeruginosa gained its hyperswarming ability through a single point mutation in a flagellar synthesis regulator (FleN). As a result, the bacteria, which usually have one single flagellum, were locked into a multi-flagellated state. They became better at moving around to cover a surface, but much worse at forming densely packed, surface-attached biofilm communities. All told, the researchers saw this new ability independently arise 20 times.
"The fact that the molecular adaptations were the same in independent lineages suggests evolution may be, to some extent, predictable," says Xavier.
The findings may be very important because biofilms are a major problem in clinical settings. Infectious biofilms are hard to remove and difficult to kill with antibiotics. Drugs that target FleN or that otherwise make bacteria better at spreading out and worse at settling down could leave them more vulnerable to antibiotics and easier to get rid of.
Source: Cell Press
Other sources
- Evolution of hyperswarming bacteria could develop anti-biofilm therapiesfrom Science DailyFri, 16 Aug 2013, 2:00:52 UTC
- Evolution of hyperswarming bacteria could develop anti-biofilm therapiesfrom PhysorgThu, 15 Aug 2013, 16:00:40 UTC